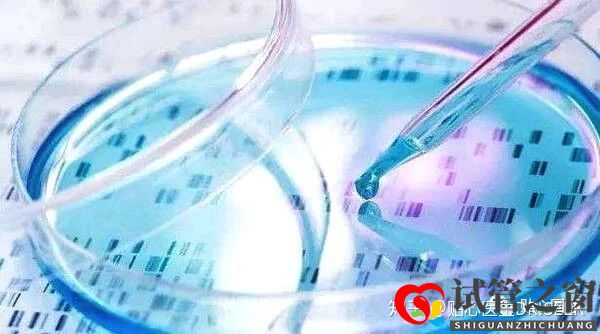
卵巢早衰做試管嬰兒的成功率(圖3) 卵巢早衰做試管嬰兒的成功率(圖3)

卵巢早衰做試管嬰兒的成功率
女性的卵巢功能是產(chǎn)生卵子和類固醇激素,這是試管成功的基本保證。如果女性在25歲以后患有卵巢功能障礙,那么我們通常會說卵巢過早衰老。女性卵巢功能的質(zhì)量對試管嬰兒的成功率有很大影響。那么日常女性如何進(jìn)行卵巢功能保養(yǎng),提高試管嬰兒的成功率呢?

在生理年齡的基礎(chǔ)上,醫(yī)生通常使用FSH,AMH和AFC來全面評估女性的卵巢年齡,這就是我們常說的生育水平!這三個指標(biāo)代表卵巢儲備水平(AMH),基底卵泡。一些(AFC - Antral Follicle Counts)和卵巢功能(FSH)。卵巢衰退患者必須首先對自己的生育計劃有合理的期望,同時建立信心。

◆◆◆
采用科學(xué)推廣計劃
體外受精(IVF)誘導(dǎo)排卵的原則是,卵巢同時補(bǔ)充外源激素可以產(chǎn)生多個卵子。起始線上的蛋越多,通過一系列受精,分裂,植入和發(fā)育過程成為胚泡的機(jī)會就越大。泰國試管推廣計劃針對每個人的身體狀況量身定制,以確保每次獲得足夠數(shù)量的雞蛋,以確保客戶的身體受到輕微傷害。
◆◆◆
身體調(diào)理,延遲下降的速度
在影響卵巢功能和女性人力的因素中,育齡和遺傳因素是不可控制的。但試管專家發(fā)現(xiàn),通過他們可以控制的飲食和生活方式調(diào)整,他們可以改善他們的身體健康并延緩卵巢衰老的速度。
◆◆◆
第三代試管PGS胚胎染色體篩查
卵巢年齡增加并且還導(dǎo)致染色體異常增加,這比我們想象的更嚴(yán)重。試管過程中的許多條件,例如不成功的胚泡培養(yǎng),非植入,植入后沒有胎心,早期停止等,可能是由于染色體異常。如果該女性的卵巢功能下降且有復(fù)發(fā)性流產(chǎn)史,她可以考慮在美國第三代試管PGS胚胎移植前進(jìn)行染色體篩查。
◆◆◆
怎樣才能每天改善卵巢功能
通過休息調(diào)理
現(xiàn)代人的生活節(jié)奏很快,許多生活方式都是不健康的,比如熬夜到凌晨,但是一大早就去上班。女性過去的長期停留對卵巢非常有害。因此,無論是25歲還是以前的女性,都要改變熬夜的習(xí)慣,確保她們有足夠的睡眠,這有利于保護(hù)卵巢。
心情愉快,放松心情
現(xiàn)代社會工作和壓力,煩躁或抑郁在女性群體中非常普遍,頻繁的情緒起伏是對卵巢非常不利的刺激。因此,無論卵巢是否過早衰老,女性都必須學(xué)會調(diào)節(jié)自己的情緒,面對生活,以積極的態(tài)度工作。保持身體和卵巢健康。
合理的鍛煉
除了飲食和睡眠,建議您多運(yùn)動,運(yùn)動對人體健康的影響同樣重要。如今,很多人都坐在辦公室里。他們大部分時間都在工作,這實(shí)際上對他們的健康非常不利。如果你長時間沒有適量的運(yùn)動,如果你的身體血液不光滑,很容易導(dǎo)致人們處于亞健康狀態(tài)甚至生病。每天適量的運(yùn)動對改善身體的循環(huán)非常有益。如果出現(xiàn)卵巢早衰的問題,主動適度運(yùn)動可以提高人體分泌水平,并且會有良性的卵巢刺激。
飲食調(diào)理
人體每天需要節(jié)食來滋養(yǎng),所以飲食對健康有很大的影響。許多人希望通過食物補(bǔ)充來調(diào)節(jié)身體。女性應(yīng)適當(dāng)增加維生素C和維生素E的攝入量,并適當(dāng)食用一些含雌激素的食物和優(yōu)質(zhì)蛋白質(zhì),這些對卵巢的維持和調(diào)理有積極作用。例如,多吃瘦肉,豆類,雞蛋,牛奶,新鮮水果和蔬菜等。

感覺有幫助,請收藏點(diǎn)個贊,謝謝大家。





